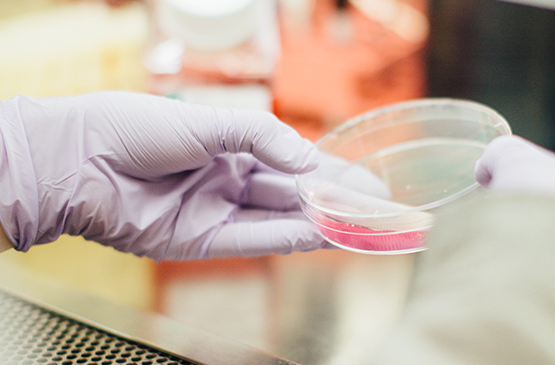
Researcher in a Lab

Long-term solutions to combating the opioid crisis will depend upon the development of novel and safer, next-generation therapies to treat both pain and addiction. To get these new innovations to the patients whose lives depend on them, the policy and regulatory environment keeps pace with advances happening in the lab.

1. Advance our understanding of the biology of pain and addiction to enable the development of innovative treatments for pain and addiction and ensure appropriate and optimal use of existing therapies
Support a more comprehensive understanding of the preclinical pain and addiction environment
Support investment in research at National Institutes of Health (NIH) and other major centers focused on the biology of pain and addiction
2. Ensure patients suffering from pain or addiction are able to receive the right treatment at the right time with the right support, without stigma
Remove coverage and reimbursement barriers that are preventing patient-centric decisions about and access to the most effective treatments for pain and addiction
Advance implementation of and adherence to laws and regulations protecting and promoting access to resources for comprehensive pain and addiction treatment

3. Stimulate research & development (R&D) of innovative treatments that effectively treat pain and opioid addiction and prevent abuse
Increase leadership engagement, expertise, and resources within the FDA & DEA to promote effective and efficient review of innovative treatments for pain and addiction
Modernize and streamline drug development and review processes to enable effective and efficient drug development and review, and stimulate investment in innovation
Establish and utilize expedited approval pathways and other incentives to stimulate innovation

Sign-up to join BIOAction, BIO's grassroots advocacy program. You will be notified about relevant policy issues where we need you to contact your lawmaker.